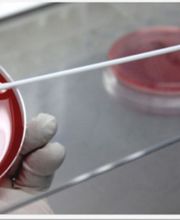

Mascolo Mario Cartolibreria
Cartoleria · Vendita al dettaglio
Via de Mattia Famiglia 29, 84078 Vallo della LucaniaRicerca
+390974273875 (Telefono)
+390974273875 (Fax)
https://www.centroantidiabeteschiavo.com (WEBSITE)
Da oltre 50 anni il Laboratorio SCHIAVO è presente a Vallo della Lucania ed ha scelto la strada del continuo aggiornamento delle tecnologie e delle metodologie di lavoro come la migliore risposta alla crescente domanda di prestazioni di qualità che lutenza formula. La costante ricerca delleccellenza, attraverso le innovazioni tecnologiche, organizzative e funzionali, ha fatto sì che il Laboratorio venisse trasferito presso i nuovi padiglioni della Casa di Cura Prof. Dott. Luigi Cobellis al fine di creare nuove ed importanti sinergie, sia dal punto di vista clinico, sia dal punto di vista diagnostico-terapeutico, garantendo così il massimo dellefficienza e della funzionalità. Negli ultimi anni il Laboratorio si è dotato di strumentazione allavanguardia e di settori specialistici che si sono affiancati a quelli che tradizionalmente hanno costituito il fulcro dellindagine strumentale ed ora il Laboratorio SCHIAVO opera in diversi ambiti della Patologia Clinica. Si eseguono le seguenti classi di esami Chimica clinica, Immunoenzimatica, Microbiologia, Ematologia, Virologia, Test per le allergie, Ormoni della fertilità, Monitoraggio della gravidanza, Funzionalità tiroidea, Markers dellepatite, Markers oncologici, Autoimmunità, Citogenetica, Citoistopatologia, Immunoistochimica e Biologia molecolare.

Piazza Vittorio Emanuele, 49, 84078 Vallo della Lucania
Cartoleria · Vendita al dettaglio
Via de Mattia Famiglia 29, 84078 Vallo della LucaniaConsulenza finanziaria
Via de Mattia Famiglia 35, 84078 Vallo della LucaniaConsulenza finanziaria
Corso de Mattia Famiglia 35, 84078 Vallo della Lucania